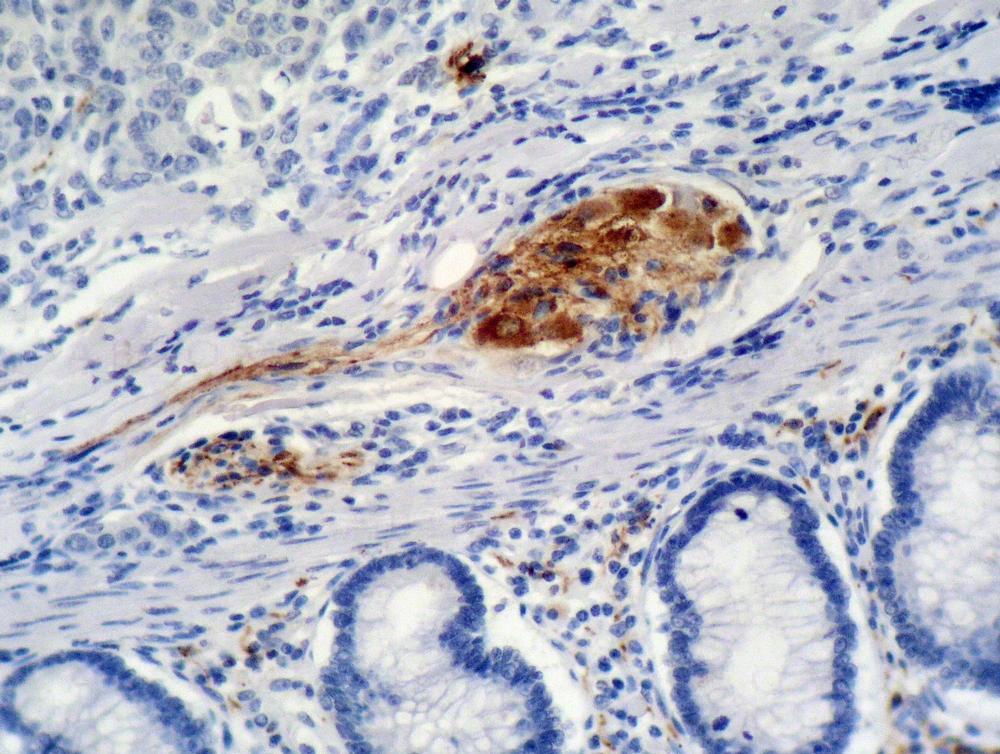

Anti-p21Waf1 Monoclonal Antibody (Clone:WA-1)(Discontinued)
Figure 1: Immunohistochemistry staining of colon carcinoma (paraffin-embedded sections) with anti-p21 (WA-1).
Roll over image to zoom in

Shipping Info:
For estimated delivery dates, please contact us at [email protected]
Format : | Purified |
Amount : | 0.1 mg |
Isotype : | Mouse IgG1 |
Purification : | Purified by protein-A affinity chromatography |
Storage condition : | Store at 2-8°C. Do not freeze. |
The tumour suppressor p21Waf1 (Wild-type p53-Activated Fragment 1; also known as Cip1, Cdk interacting protein, or SDI 1) is a cyclin-dependent kinase (Cdk) inhibitor, which is expressed by involvement of p53, Egr-1, AP2, STATs or other transcription factors upon various stimuli resulting in cell cycle arrest. Through its N-terminal domain p21Waf1 inhibits Cdk activity, whereas through the C-terminal domain it inhibits the activity of PCNA (proliferating cell nuclear antigen) to activate DNA replication. Cytosolic location of p21 counteracts its inhibitory activities.
Immunofluoroscence Immunohistochemistry Positive tissue: colon carcinoma
For Research Use Only. Not for use in diagnostic/therapeutics procedures.
Subcellular location: | Cytoplasm, Nucleus |
Post transnational modification: | Acetylation leads to protein stability. Acetylated in vitro on Lys-141, Lys-154, Lys-161 and Lys-163. Deacetylation by HDAC1 is prevented by competitive binding of C10orf90/FATS to HDAC1 (By similarity). |
Tissue Specificity: | Expressed in all adult tissues, with 5-fold lower levels observed in the brain. |
BioGrid: | 107460. 284 interactions. |
There are currently no product reviews
|